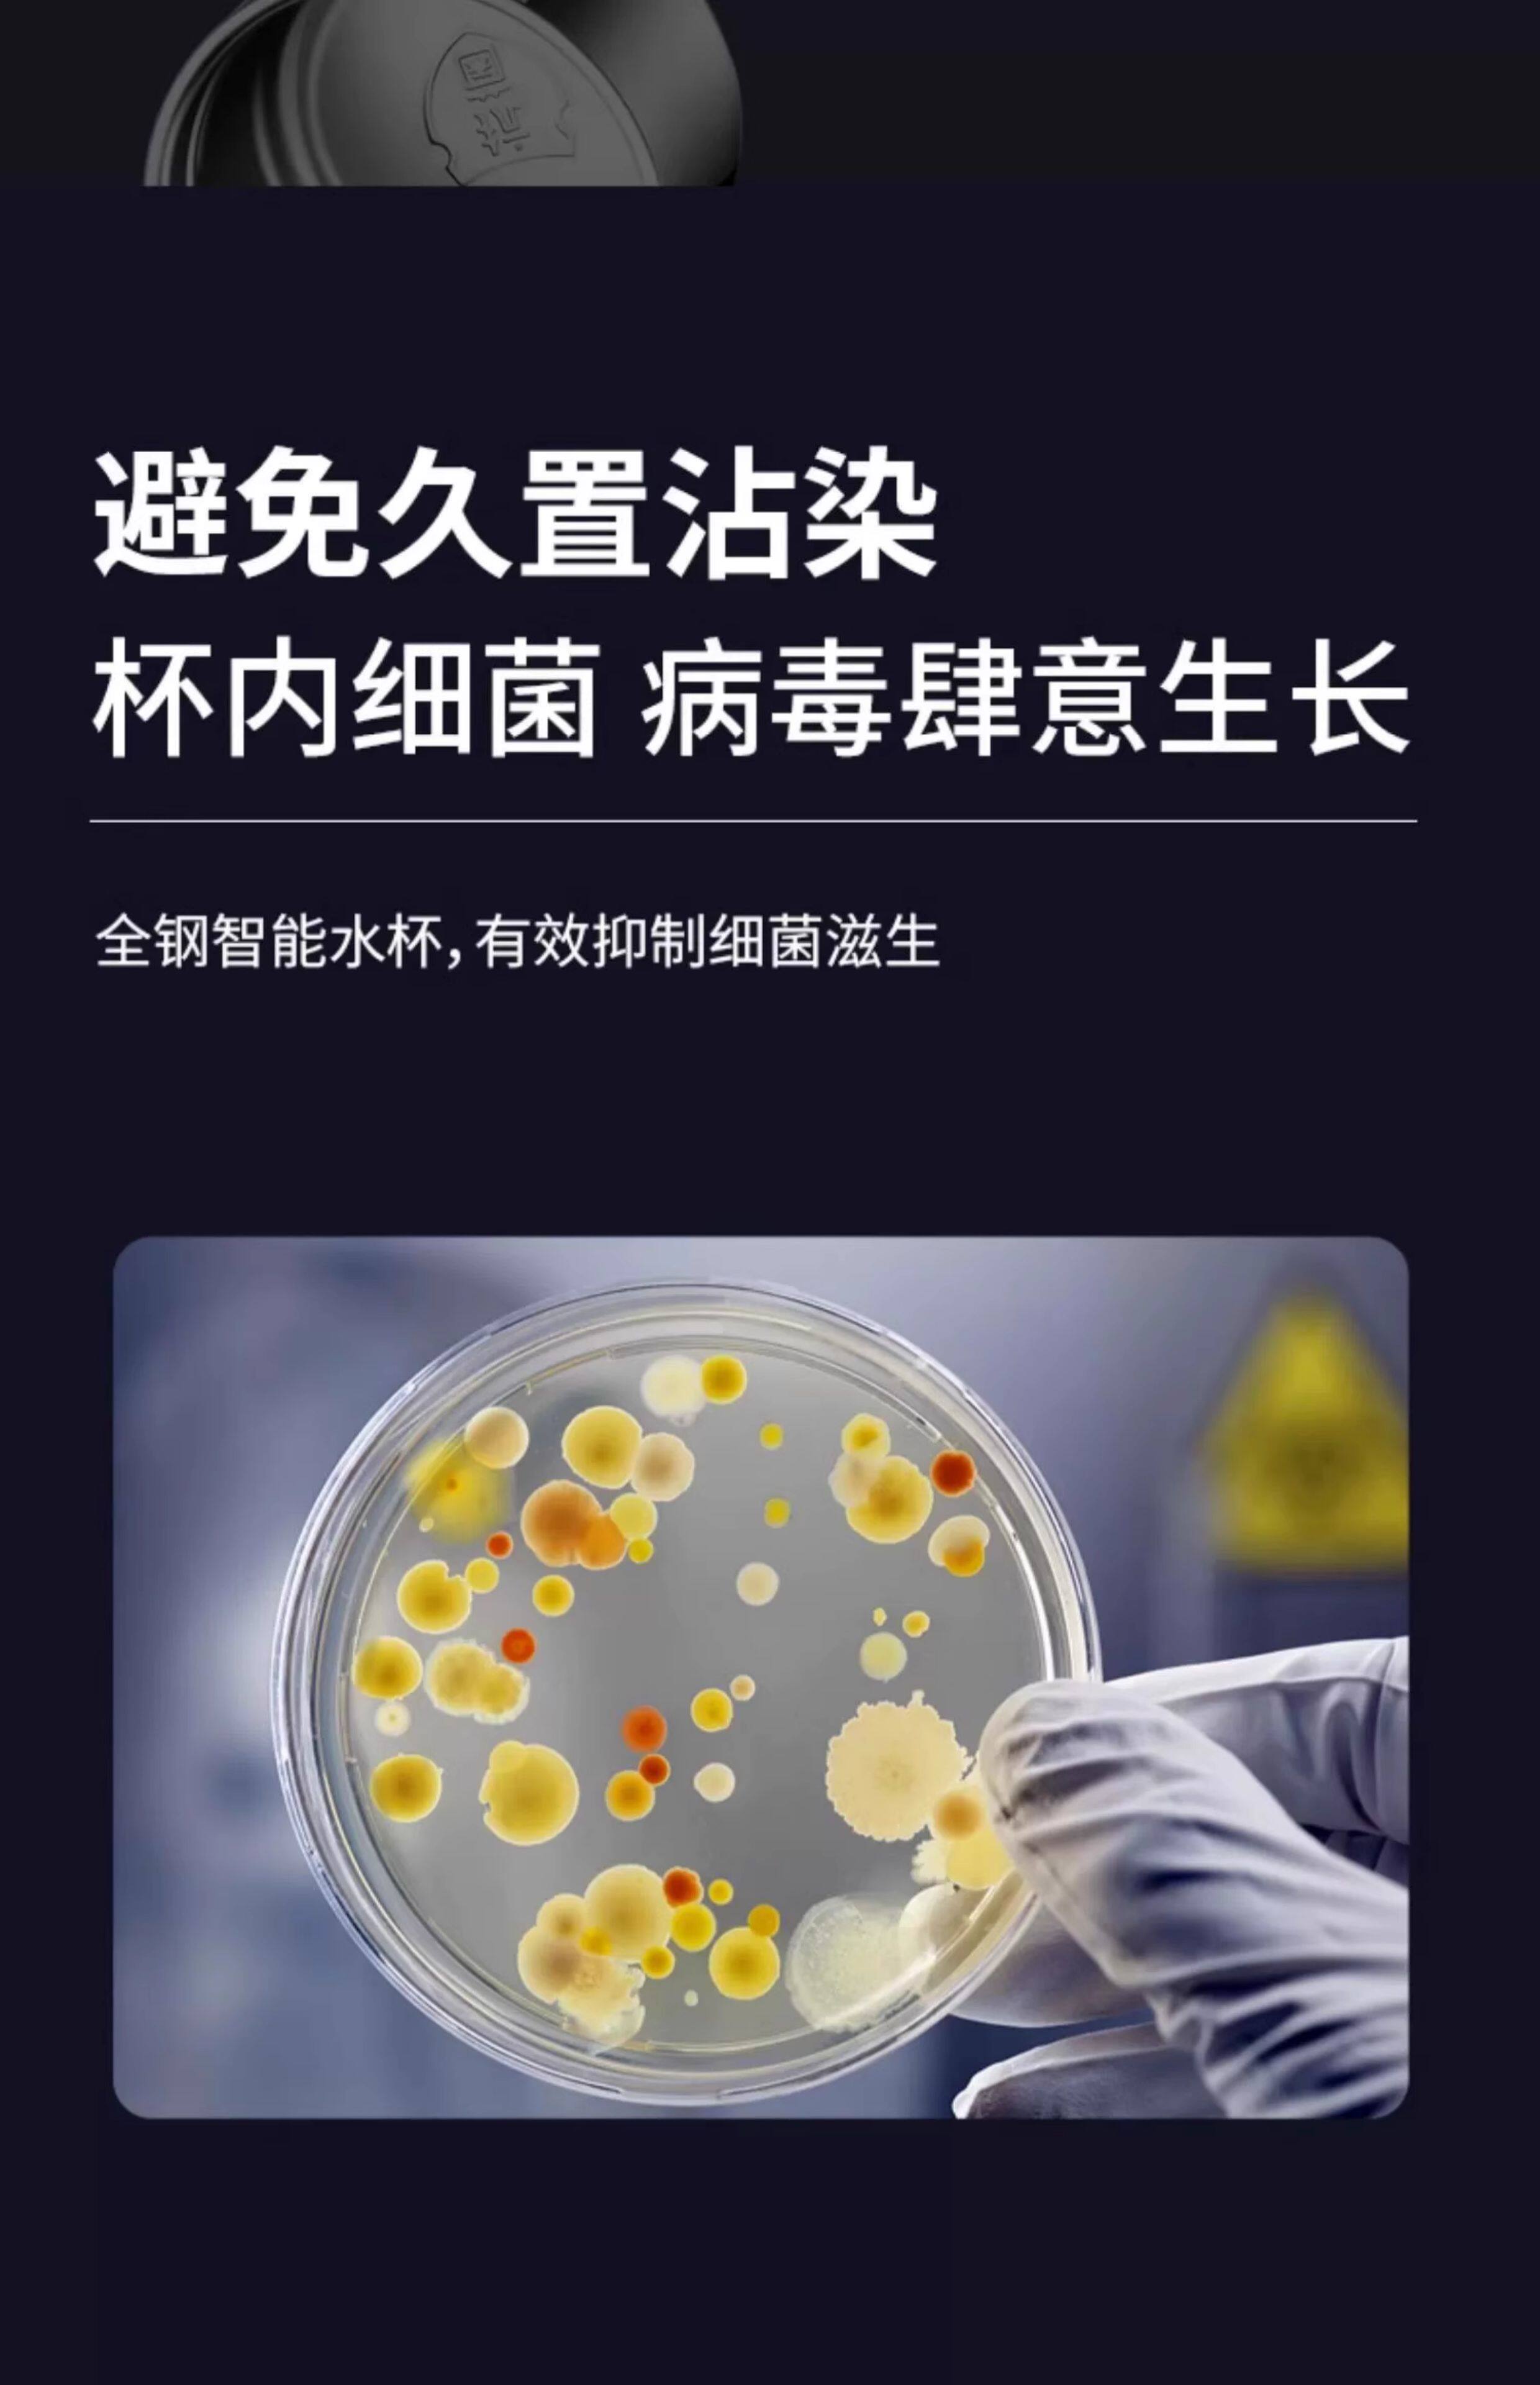

Вместительный и большой стакан подходит для мужчин и женщин, чайник из нержавеющей стали, летняя чайная чашка

Цена: 1 372руб. (¥64.9)
Артикул: 759047317369
Вес товара: ~0.7 кг. Указан усредненный вес, который может отличаться от фактического. Не включен в цену, оплачивается при получении.
Описание товараPGltZyBzcmM9Imh0dHBzOi8vaW1nLmFsaWNkbi5jb20vaW1nZXh0cmEvaTMvMjQ1Mjk5OTAwNS9PMUNOMDFkSkRNVmoyR09MZDFLZmRtbl8hITI0NTI5OTkwMDUuanBnIj48aW1nIHNyYz0iaHR0cHM6Ly9pbWcuYWxpY2RuLmNvbS9pbWdleHRyYS9pMS8yNDUyOTk5MDA1L08xQ04wMU1WbENpODJHT0xkMmVBVUx2XyEhMjQ1Mjk5OTAwNS5qcGciPjxpbWcgc3JjPSJodHRwczovL2ltZy5hbGljZG4uY29tL2ltZ2V4dHJhL2kyLzI0NTI5OTkwMDUvTzFDTjAxMVdmOFlvMkdPTGQyTFZreVRfISEyNDUyOTk5MDA1LmpwZyI+PGltZyBzcmM9Imh0dHBzOi8vaW1nLmFsaWNkbi5jb20vaW1nZXh0cmEvaTEvMjQ1Mjk5OTAwNS9PMUNOMDFoZDFyVU0yR09MZDE4RWt5dV8hITI0NTI5OTkwMDUuanBnIj48aW1nIHNyYz0iaHR0cHM6Ly9pbWcuYWxpY2RuLmNvbS9pbWdleHRyYS9pMi8yNDUyOTk5MDA1L08xQ04wMUxHQTNtbzJHT0xkMXA4NjFHXyEhMjQ1Mjk5OTAwNS5qcGciPjxpbWcgc3JjPSJodHRwczovL2ltZy5hbGljZG4uY29tL2ltZ2V4dHJhL2kzLzI0NTI5OTkwMDUvTzFDTjAxTWxxMmtFMkdPTGQxczNaNkdfISEyNDUyOTk5MDA1LmpwZyI+PGltZyBzcmM9Imh0dHBzOi8vaW1nLmFsaWNkbi5jb20vaW1nZXh0cmEvaTQvMjQ1Mjk5OTAwNS9PMUNOMDFDSFB4bU0yR09MZDFGcEFxbl8hITI0NTI5OTkwMDUuanBnIj48aW1nIHNyYz0iaHR0cHM6Ly9pbWcuYWxpY2RuLmNvbS9pbWdleHRyYS9pMy8yNDUyOTk5MDA1L08xQ04wMUlhNFNKRTJHT0xkMThEa2I4XyEhMjQ1Mjk5OTAwNS5qcGciPjxpbWcgc3JjPSJodHRwczovL2ltZy5hbGljZG4uY29tL2ltZ2V4dHJhL2kxLzI0NTI5OTkwMDUvTzFDTjAxSEhhdWJiMkdPTGN6WkwwYVBfISEyNDUyOTk5MDA1LmpwZyI+PGltZyBzcmM9Imh0dHBzOi8vaW1nLmFsaWNkbi5jb20vaW1nZXh0cmEvaTEvMjQ1Mjk5OTAwNS9PMUNOMDFnVVVnYkgyR09MY3pWQVRSTF8hITI0NTI5OTkwMDUuanBnIj48aW1nIHNyYz0iaHR0cHM6Ly9pbWcuYWxpY2RuLmNvbS9pbWdleHRyYS9pMy8yNDUyOTk5MDA1L08xQ04wMVdYSGNGcDJHT0xkMUtoUzJRXyEhMjQ1Mjk5OTAwNS5qcGciPjxpbWcgc3JjPSJodHRwczovL2ltZy5hbGljZG4uY29tL2ltZ2V4dHJhL2kzLzI0NTI5OTkwMDUvTzFDTjAxMkE5OTk3MkdPTGQxczVpOWNfISEyNDUyOTk5MDA1LmpwZyI+PGltZyBzcmM9Imh0dHBzOi8vaW1nLmFsaWNkbi5jb20vaW1nZXh0cmEvaTIvMjQ1Mjk5OTAwNS9PMUNOMDFMdG80Y0YyR09MZDBad0d5TV8hITI0NTI5OTkwMDUuanBnIj48aW1nIHNyYz0iaHR0cHM6Ly9pbWcuYWxpY2RuLmNvbS9pbWdleHRyYS9pNC8yNDUyOTk5MDA1L08xQ04wMVluUktHYzJHT0xkMUtnaUpEXyEhMjQ1Mjk5OTAwNS5qcGciPjxpbWcgc3JjPSJodHRwczovL2ltZy5hbGljZG4uY29tL2ltZ2V4dHJhL2kzLzI0NTI5OTkwMDUvTzFDTjAxNFA4b05WMkdPTGQxczR5UmRfISEyNDUyOTk5MDA1LmpwZyI+PGltZyBzcmM9Imh0dHBzOi8vaW1nLmFsaWNkbi5jb20vaW1nZXh0cmEvaTEvMjQ1Mjk5OTAwNS9PMUNOMDFmVXZLVlMyR09MZDJMVUROTV8hITI0NTI5OTkwMDUuanBnIj48aW1nIHNyYz0iaHR0cHM6Ly9pbWcuYWxpY2RuLmNvbS9pbWdleHRyYS9pNC8yNDUyOTk5MDA1L08xQ04wMXl6aGwzWjJHT0xjeXhEanVvXyEhMjQ1Mjk5OTAwNS5qcGciPjxpbWcgc3JjPSJodHRwczovL2ltZy5hbGljZG4uY29tL2ltZ2V4dHJhL2kzLzI0NTI5OTkwMDUvTzFDTjAxZ1NicHNPMkdPTGQwWnhEQmRfISEyNDUyOTk5MDA1LmpwZyI+PGltZyBzcmM9Imh0dHBzOi8vaW1nLmFsaWNkbi5jb20vaW1nZXh0cmEvaTMvMjQ1Mjk5OTAwNS9PMUNOMDF4bktMcnUyR09MZDJlQ3U0MV8hITI0NTI5OTkwMDUuanBnIj48aW1nIHNyYz0iaHR0cHM6Ly9pbWcuYWxpY2RuLmNvbS9pbWdleHRyYS9pMi8yNDUyOTk5MDA1L08xQ04wMTZWeGZ0RzJHT0xkMUtpU1BpXyEhMjQ1Mjk5OTAwNS5qcGciPjxpbWcgc3JjPSJodHRwczovL2ltZy5hbGljZG4uY29tL2ltZ2V4dHJhL2kxLzI0NTI5OTkwMDUvTzFDTjAxbmZuVEg2MkdPTGQwbTA4d2RfISEyNDUyOTk5MDA1LmpwZyI+PGltZyBzcmM9Imh0dHBzOi8vaW1nLmFsaWNkbi5jb20vaW1nZXh0cmEvaTEvMjQ1Mjk5OTAwNS9PMUNOMDFMTUhlVE0yR09MY3VkanJzM18hITI0NTI5OTkwMDUuanBnIj48aW1nIHNyYz0iaHR0cHM6Ly93d3cubzBiLmNuL2kucGhwP3QucG5nJnJpZD1ndy00LjY4NGQwNTA3MDVkOGUmcD0yNDIwOTE3NzE3Jms9ZS5jb20mdD0xNzQ5ODc4MDI3IiBzdHlsZT0iZGlzcGxheTpub25lIj4=
Продавец:欧诗玛旗舰店
Адрес:Чжэцзян
Рейтинг:

Всего отзывов:0
Положительных:0
Выберите вариацию / цвет
Добавить в корзину
- Информация о товаре
- Фотографии
| Цвет: | 600 мл, Черный, 600 мл, Стальной цвет 600мл + сепаратор для чая, Черный, 600 мл, Стальной цвет 600 мл + сепаратор для чая + рукав для чашки + щеточка для чашки, Черный 600 мл + сепаратор для чая + крышка для чашки, 800 мл, Черный, 800 мл, Стальной цвет 800мл + сепаратор для чая, Черный, 800 мл, Стальной цвет 800мл + сепаратор для чая + крышка для чашки, Черный 800 мл + сепаратор для чая + крышка для чашки, 1000 мл, Черный, 1000 мл, Стальной цвет 1000мл + сепаратор для чая, Черный, 1000 мл, Стальной цвет 1000мл + сепаратор для чая + крышка для чашки, Черный, 1000 мл, 1500 мл, Черный, 1500 мл, Стальной цвет 1500мл + сепаратор для чая, Черный, 1500 мл, Стальной цвет 1500мл + сепаратор для чая + крышка для чашки, Черный, 1500 мл, 2000 мл, Черный, 2000 мл, Стальной цвет 2000мл + сепаратор для чая, Черный, 2000 мл, Стальной цвет 2000мл + сепаратор для чая + крышка для чашки, Черный, 2000 мл |